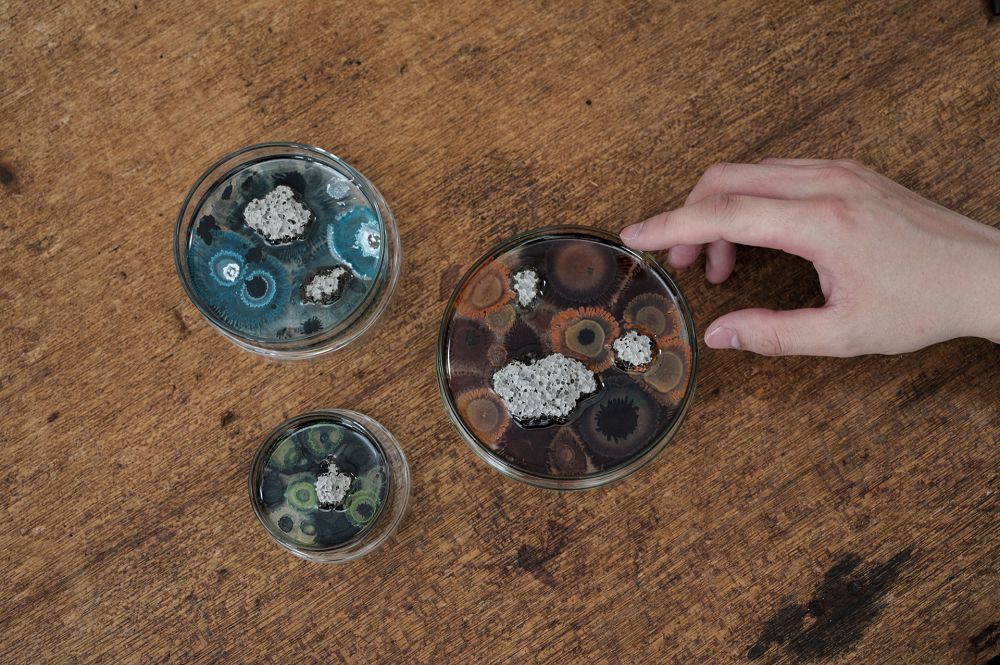
絕美微觀玻璃擴香座！The New Normal氣味培養皿、蜂巢擴香石共譜沉浸嗅覺體驗
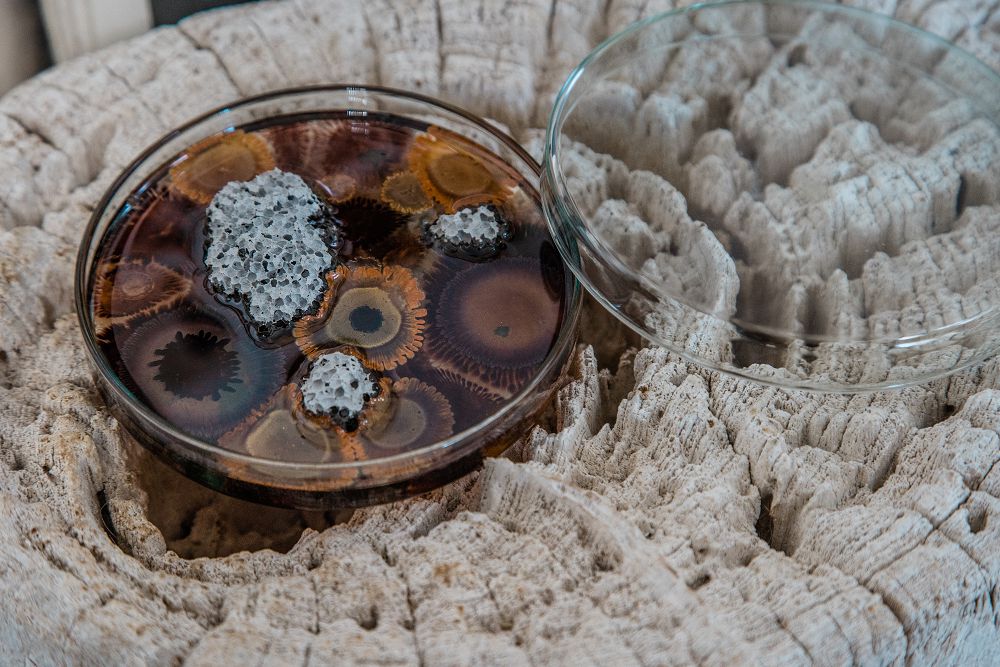
絕美微觀玻璃擴香座！The New Normal氣味培養皿、蜂巢擴香石共譜沉浸嗅覺體驗

以植物設計與藝術創作聞名,質物霽畫主理人李霽在2021年創立全新家具品牌「WASTE」,並攜手台灣茶香水品牌P.Seven以及質物霽畫團隊製作,加上春池玻璃研發的科技綠能建材「發泡玻璃」作為擴香石,推出「 The New Normal」 (新常態)氣味培養品擴香!
「WASTE」希望藉由產業之間彼此串連的運作機制,將建設產業、時尚產業、科技技術與實驗機構等不同領域的廢棄物進⾏收集以及整理,透過了解材料的本質,賦予其新的價值和功能性;並透過美學的再現,找到屬於未來環境的混合性設計語言。


作為WASTE首個系列新作,品牌與屬於東方的香水品牌 P.Seven攜手合作,推出醞釀已久的氣味培養品擴香;之所以以「 The New Normal (新常態)」為產品名,指的是處於後疫情時代的我們,在回歸生命與自然體悟時所產生的新常態。 WASTE 以藝術的角度切入龐大的議題,將情感經驗轉化為氣味,讓人人都能創造自己的想像空間。

大尺寸的氣味培養皿適合放在各種桌面,能做為辦公室良伴,看來療癒又吸睛。

中尺寸的氣味培養皿,適合擺床頭,讓氣味培養皿的香氣伴你入睡。
結合創意、家飾、氣味、永續,「 The New Normal 氣味培養皿 」有別於一般擴香產品,團隊將實驗室中的微觀世界,轉化成獨一無二的藝術品,並選用的友善環境的原料,透過 P.Seven 專業調香師對於氛圍呈現的理解,設計兩款限量擴香淨油,更值得一提的是-首創以春池玻璃研發的科技綠能建材「發泡玻璃」作為擴香石,不僅環保無毒,蜂巢狀孔洞也達到很好的擴香效果。

小尺寸的氣味培養皿花紋與顏色有最多的變化,是放客廳和玄關的首選,也可以放在較淺的層架,或是洗手台檯面,連浴室也能一直香香的!
五大特點
- 三種尺寸|適合各種空間
三種尺寸的規格比較圖,可依照想擺放的空間做對照。
為了滿足不一樣的消費需求和場所,氣味培養皿推出 S、M、L 三種規格,讓陳列配置更有層次。可裝飾於工作桌、床頭桌、玄關、客廳、浴室等,提升居家設計質感。
- 多種配色|暈染的色澤讓你找到屬於自己的微觀世界

氣味培養皿猶如藝術品,每一個都有自己的個性。

精心製作每一個培養皿的花色與紋理,細節像畫一般豐富。
將實驗室中的微觀,轉化爲視覺的釋義,色彩彼此之間的排列組合以轉譯菌的存在密碼與圍繞的哲理。為了帶給大家不同層次的嗅覺體驗,我們設法以藝術品的角度去呈現這項商品。因此,每一件培養皿都是純手工製作的。從培養皿內的顏色到暈染的花紋,都不會有重複,是獨一無二的存在。
- 氣味原料環保|與香水品牌 P.Seven 聯名,使用對環境友善香氣

P.Seven 公司研隊堅強,擁有多項芳療師與講師執照,品牌強調使用環境友善的香精,非一般化工香料可比。這次合作研發的『擴香淨油』內含植物精油與天然單體,以其最精簡的配方精萃而成,原始與赤裸的分子賦予氣味更多微觀的想像與體驗。


WASTE 邀請 P.Seven 調配兩款專屬於『 The new normal 』系列商品的擴香淨油。透過專業調香師對於氛圍呈現的理解,悉心設計了『頹敗中的微光』和『無人之境』兩支情境式香氣。『頹敗中的微光』重現了雨後的濕潤,蘚苔和沼澤草根植物布滿岩石,光束穿越樹冠羞避的景象;『無人之境』傳遞著寧靜通透的情境,猶如置身無重力的宇宙,徜徉於中性自在的狀態。
- 全新綠能擴香|全新擴香材質,蜂巢狀孔洞達到很好的擴香效果

這些發泡後形成的孔洞,能阻絕熱源和聲音,是相當有市場潛力的環保無毒建材,同時也是擴香能力極佳的介質。
首創以春池玻璃研發的科技綠能建材「發泡玻璃」作為產品的擴香載體。發泡玻璃磚的原理是將面板玻璃研磨成粉末後,混合水泥,再經過發泡的程序製成,使磚體內部形成蜂巢的孔狀結構。這些發泡後形成的孔洞,能阻絕熱源和聲音,是相當有市場潛力的環保無毒建材,同時也是擴香能力極佳的介質。
- 操作簡易|直覺性操作,一秒就上手

只需定期將擴香淨油均勻滴滿發泡玻璃,即可讓空間保持芬芳。
氣味培養皿附玻璃蓋子,可在不需擴香時減緩香氣的消耗,容器實用好收納。
氣味培養皿有著直覺式的操作方式,滴入 5-8 滴擴香淨油即可讓香氣充滿空間,並附玻璃蓋子,可在不需擴香時減緩香氣的消耗,容器實用好收納。
│ 關於 WASTE │
2021 創立的家具品牌,貫徹的品牌核心__解決當今過多廢棄物與環境產生的負荷。藉由產業之間彼此串連的運作機制,將建設產業、時尚產業、科技技術與實驗機構等不同領域的廢棄物進⾏收集以及整理,透過了解材料的本質,賦予其新的價值和功能性;並透過美學的再現,找到屬於未來環境的混合性設計語言。
│ 關於 P.Seven │
P. Seven 創辦人潘雨晴,鑽研茶道多年,其對嗅覺藝術涵養與敏銳度,創辦了屬於東方的香水品牌,更被日本媒體譽為天才氣味設計師,由其帶領的調香師團隊,擁有法國調香學院 ISIPCA 文憑、英國國際芳療師協會認證,及美國 NAHA 國家整體芳療協會芳療師執照。使用原料皆符合 IFRA 規範,秉持研發對人體、動物、環境友善的原料,是 P.Seven 最柔軟的初心。
│關於質物霽畫│
成立於 2013 年,質物霽畫 BOTANIPLAN VON LEE CHI 探索植物與空間的深化關係,持續延展對於生命與自然的體悟,以獨特創作語匯穿透實體、超越形式與認同的枷鎖,直達心底一次次的美感經驗對話。結合建築背景,透過設計案、教學、創作、產品發展,組接從建築架構、生活層面、到植物藝術的融合軌跡,從理念上不斷嘗試與傳遞,透過本質思考、現象分析、和技術研究,轉化作品的藝術化成果。
│關於 W 春池計畫 / W Glass Project│
串聯玻璃工藝、設計、議題與材料,探索「 回收 」與「 創造」之間的矛盾與共生。以製造玻璃器物的原料就是玻璃本身為題,在建構與破壞的同時,尋求有意義的無限循環。
Info|The New Normal 氣味培養皿
執行單位:WASTE
協力製作:質物霽畫
發泡玻璃:春池玻璃
氣味訂製:P.Seven
更多資訊:The New Normal 氣味培養皿 嘖嘖募資平台/WASTE 粉專、Instagram/P.Seven 官網、粉專/質物霽畫 官網、粉專/W春池計畫 官網、粉專/有家攝影工作室 官網、粉專
延伸閱讀
電廠煤灰竟可做擴香石!台電文創聯手金馬獎,結合絕版舊公文紙推出「煤灰擴香石筆記本」
香氛控注意!前所未見,完美演繹擴香結合無線隨充的全新力作! 「ZENLET 無線隨充攜香器
不怕你養壞的葉葉YEYE「革植擴香」,植出你的滿室綠意馨香
追蹤大人物
大人物 Telegram |大人物FB|大人物IG |大人物LINE@
若想分享創意或新聞訊息,歡迎寄至 [email protected]